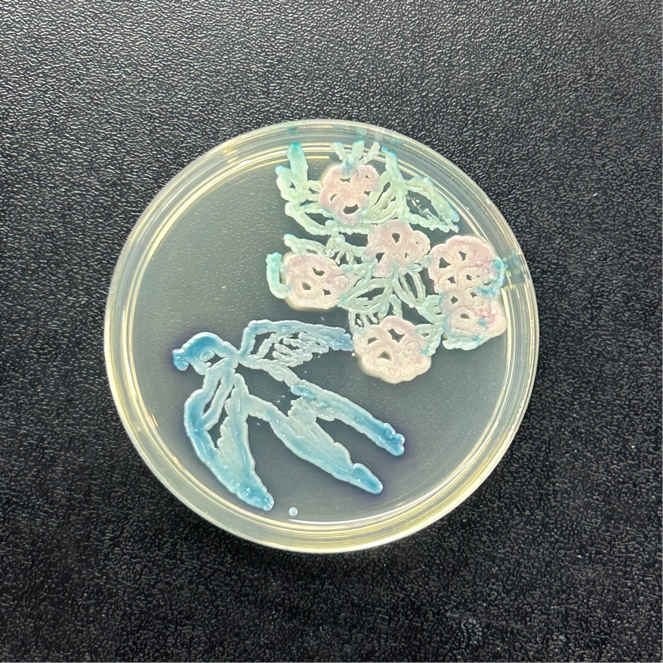
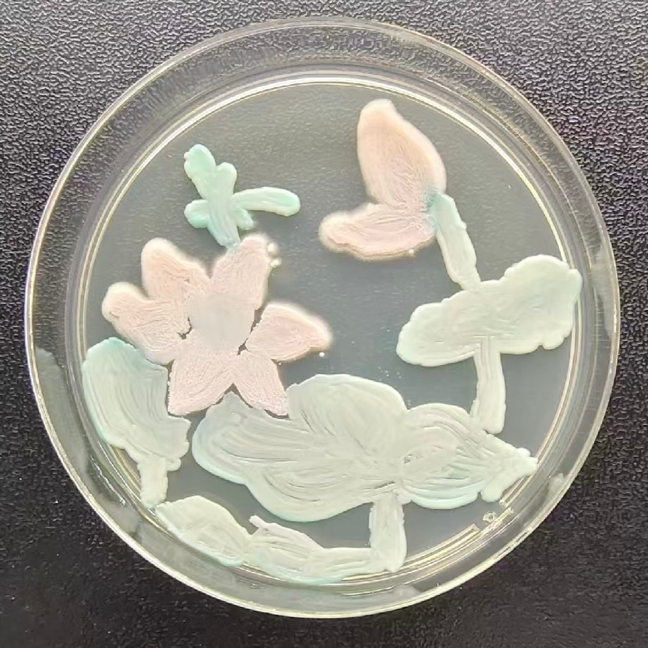

“以方寸之地,展现世间万变”,在9-10月江苏省微生物学会举办的微生物培养皿艺术大赛中,艾弗森贝博ballbet官网沈与乐、周梦寒、宋新宇、胡皓文、陈心怡、梁雪梅、王星玥、张润青同学在高大庆、袁晨燕等老师的指导和带领下,积极参与本次大赛,用菌种在培养皿中作画,展现自然的魅力。在本次过程中,同学们在老师的帮助下培育各类菌种并选择菌种色彩,迭代使用工具,力求至善,在自然中感悟,在自然中创造,最终创作5幅作品,获得了二、三等奖的好成绩。
在本次竞赛中,几位学生不仅有机会重新审视和加深了他们对微生物学的知识,而且他们对各种微生物的培养特性有了更加深入的理解。通过这次合作创作的经历,他们不仅在思维上得到了锻炼,还在艺术创作上有所突破,感受到了科学与艺术的美妙结合。从微观层面的微生物接种技术到宏观层面的色彩搭配、线条勾勒和纹理表现,他们不仅充分展现了丰富的想象力和创造力,而且还展示了微生物学的无限魅力和可能性。


二等奖作品《为有暗香来》


三等奖作品《兰生幽谷》

三等奖作品《喜燕报春》


三等奖作品《蓝鹟啼翠柳》

三等奖作品《小荷才露尖尖角》

搜索